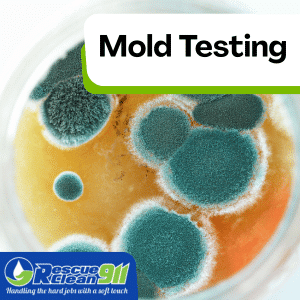
indoor environment where mold grows

Green Mold: What It Is & How To Get Rid Of It
Mold is a common household nuisance, but few people realize the extent of its potential for harm. Part of the fungus family, molds play an essential role in the breakdown of leaves, wood, and other plant debris.
However, when they immigrate from their natural environment to our homes, they can become unwanted guests, causing both health problems and property damage.
Green mold is not a single type of species. Instead, this term is often used to refer to several species of fungi with a similar green hue. These molds are found both indoors and outdoors, thriving in damp and poorly ventilated areas.
While it might seem like an ordinary, everyday inconvenience, green mold can pose serious health risks. Having an understanding of what green mold is, its risk factors, and how to safely handle it is highly beneficial for every homeowner.
In the following sections, we will discuss how to identify green mold, the dangers it can pose to your health, effective strategies for removing it from your home, and, importantly, how to prevent it from coming back.
Identifying & Understanding Green Mold
If you’ve noticed a distinct greenish hue on your walls, ceilings, or other damp areas in your home, you might be dealing with a green mold infestation. The most common causes of green mold are excess moisture, poor air movement, and lack of ventilation in humid areas.
 Green mold refers to a variety of mold species that appear green, including Aspergillus, Cladosporium, and Talaromycosis. Each of these could potentially pose health risks, especially to those with mold allergies or compromised respiratory systems.
Green mold refers to a variety of mold species that appear green, including Aspergillus, Cladosporium, and Talaromycosis. Each of these could potentially pose health risks, especially to those with mold allergies or compromised respiratory systems.
- Aspergillus often appears yellow green or blue-green and is commonly found on spoiled foods, damp walls, and HVAC systems.
- Cladosporium ranges from olive green to blackish and grows on wood, fabrics, and carpets.
- Penicillium typically has a blue-green or greenish velvety texture and is commonly found on water-damaged materials.
All molds require a moisture source and organic material to grow. If left untreated, mold can weaken drywall, rot wood, and lower indoor air quality, making it clear why green mold dangerous exposure is a real concern.
Detecting Green Mold
Green mold isn’t always easy to detect or differentiate from other types of mold or potentially harmful microscopic organisms. It might be confused with blue-green algae, also known as cyanobacteria, which is predominant in water bodies and can also cause several health problems.
While green mold exclusively thrives on organic material in damp areas, cyanobacteria blooms occur in various freshwater bodies, especially during the early fall, when the nutrient levels are high.
Mold Testing
Mold testing plays a crucial role in identifying whether an unknown substance is green mold or something else. It can also help determine the species of mold.
Mold testing plays a crucial role in identifying whether an unknown substance is green mold or something else. It can also help determine the species of mold.
For instance, Cladosporium, a type of green mold, may exhibit different hues, while cyanobacteria blooms can give off a blue-green color. Therefore, mold testing ensures accurate identification, preventing harmful exposure, and facilitating quick remediation.
Where to Look for Green Mold
An essential aspect of understanding green mold is knowing where it thrives and why. Dark, damp, and unventilated areas provide the perfect environment for mold growth, such as basements, bathrooms, kitchens, or any other places where a water leak may occur.
By knowing what green mold is and how it forms, you can catch it in the early stages before it escalates into a large mold infestation, damaging property, and affecting health among those exposed.
From this point on, awareness is the key. The best weapon you have against green mold is quickly recognizing and addressing it.
If you suspect a mold infestation in your home, getting help from a professional remediation company like Rescue Clean 911 is a wise decision. We have the necessary knowledge, expertise, and tools to handle mold infestations and make your home safe and healthy again.
Is Green Mold Dangerous Compared to Black Mold?
Yes, Green mold exposure can have serious potential health effects, especially for infants, elderly individuals, pregnant women, and those with weakened immune systems. Some molds produce mycotoxins that may cause:
 Headaches, fatigue, and cognitive issues
Headaches, fatigue, and cognitive issues- Respiratory symptoms like a runny nose, wheezing, or coughing
- Neurological problems or liver damage in severe cases
Even in healthy individuals, exposure can trigger mild irritation or worsen allergies. Left untreated, green mold can compromise your home’s structure, and mold can cause long-term damage.
READ: Causes Of Black Mold In Insulation And How to Prevent It
Understanding the Risks: Why Green Mold Thrives and Spreads
Green mold thrives in damp, warm environments where spores can easily reproduce. Like all molds, it spreads through tiny spores that travel through the air and settle on surfaces, waiting for moisture to begin growth.
Early detection and proper cleaning methods, including a commercial mold cleaner, can help control infestations and kill mold before it spreads further.
Even small infestations can escalate if left unchecked, creating both health hazards and structural mold problems, making it crucial to prevent future mold growth.
Causes and Environment
Green mold growth is influenced primarily by environmental factors. Recognizing these triggers is the first step toward effective prevention.
 What Causes Green Mold Growth?
What Causes Green Mold Growth?
Several conditions create an ideal environment for green mold growth:
- Excess moisture: Leaky roofs, pipes, or flooding provide water for spores to colonize.
- High humidity levels: Bathrooms, kitchens, and basements are common hotspots.
- Organic materials: Wood, paper, and fabric serve as food sources for mold.
Understanding these triggers allows homeowners to implement strategies to prevent green mold growth and reduce the risk of future mold growth in the home.
Where Green Mold Commonly Appears in Homes
Knowing where to find green mold is crucial for prevention and removal. Green mold dangerous growth, is commonly found in:
- Basements and crawlspaces near sump pumps
- Bathrooms with high humidity and poor air movement
- Around leaky windows or moisture source points like pipes and roofs
- HVAC systems and vents
- Wood, fabrics, carpets, and furniture are exposed to damp conditions
Condensation on cold surfaces, such as windows and pipes, provides an ideal environment for mold spores. Indoor relative humidity above 50% can allow mold to grow rapidly. Using dehumidifiers, trimming vegetation near the house, and improve ventilation can help limit growth.
Once you’ve identified where mold thrives, learn what kills mold the best—sunlight or bleach—to keep your home safe and clean
The Role of Poor Ventilation and Moisture in Fungal Development
One of the most common culprits behind green mold thrives is poor ventilation. When air cannot circulate properly, moisture lingers on walls, ceilings, and floors, creating a perfect environment for spores to grow.
Without proper airflow or dehumidification, mold thrives, potentially spreading to hidden areas like HVAC systems and behind drywall. Proper ventilation is key to preventing future mold growth.
READ: Does Ammonia Kill Mold?
 Green Mold vs Algae, Mildew, and Other Growths
Green Mold vs Algae, Mildew, and Other Growths
Not all green growth is harmful. It’s important to find green mold and differentiate it from harmless algae or mildew:
- Mildew usually appears powdery and grows on the surface of paper, fabrics, or shower tiles.
- Algae tends to form slimy green layers on exterior siding or roofs and is less likely to cause potential health effects.
- Green mold, however, is a fungal growth that penetrates porous surfaces and can cause health issues if spores are inhaled.
Using baking soda, white vinegar, or hydrogen peroxide solutions can help remove mold safely, while algae may respond to power washing alone. Recognizing these differences ensures you are not fighting a losing battle unnecessarily.
Recognizing a Structural Mold Problem: Existing Mold on Wood
Wooden surfaces are particularly vulnerable to mold colonization. Existing mold on wood can weaken structural integrity over time, causing warping, discoloration, and rot.
Using a commercial mold cleaner can help kill mold effectively, but early action is key to preventing further damage. Identifying and addressing green mold early is essential for both health and structural safety, and taking steps to prevent it reduces the likelihood of future mold growth.
If you spot mold on wood, it’s important to know what happens if mold is found during a home inspection to protect both your health and your property.
Health Risks Associated with Green Mold
While the exact health risks can vary from one type of green mold to another, prolonged or continuous exposure to its spores can undoubtedly trigger health problems.
 The mold spores, invisible to the naked eye, can easily become airborne and inhaled, which can result in various allergic reactions and exacerbate respiratory problems among those exposed.
The mold spores, invisible to the naked eye, can easily become airborne and inhaled, which can result in various allergic reactions and exacerbate respiratory problems among those exposed.
Respiratory System Issues
One of the most common health issues caused by green mold exposure is difficulty breathing. This symptom is particularly pronounced among people with asthma or allergic rhinitis, as exposure to green mold can trigger asthma attacks or cause persistent sneezing. In extreme cases, it can also result in a serious lung infection.
Chronic Health Effects
In addition to respiratory issues, mold exposure can also have subtle but significant impacts on the nervous system. Long-term exposure to some types of mold may lead to chronic health effects like fatigue, headaches, and even nervous system disorders over time. Skin irritation is another common reaction, potentially presenting as rashes, blisters, or dermatitis.
Understanding the health risks of mold also means knowing whether heat can kill mold, which can help in preventing its harmful effects.
Factors that Can Make Health Issues Worse
It’s also important to note the role that environmental conditions play in the adverse effects of green mold. High humidity levels, for instance, can encourage rapid mold growth and the proliferation of harmful algae blooms, which can exacerbate the negative impact of green mold on health.
Understanding these health risks helps underline the importance of immediate mold remediation. By removing green mold from your home, you can eliminate these health risks and ensure your living space is safe and comfortable.
At Rescue Clean 911, we prioritize your health and safety, providing comprehensive mold remediation services to protect you and your family from the potential dangers of green mold.
Effective Removal Strategies for Green Mold
As overwhelming as a mold infestation may seem, it can be managed effectively with the right approach and, in most cases, professional assistance. The first step is to understand the extent of the infestation, which may call for professional mold testing. This will provide a clear idea of the type of green mold you are dealing with, its concentration, and the most effective remediation methods.
 Small Infestations of Green Mold
Small Infestations of Green Mold
For smaller infestations, a DIY approach may be sufficient. This often involves scrubbing the affected areas with a bleach solution, which can kill the mold and disinfect the non-porous surfaces.
But remember to wear protective clothing and a mask to prevent direct contact and inhalation of spores during this process.
Large Infestations of Green Mold
When dealing with a more extensive or hard-to-reach mold infestation, it’s in your best interest to seek professional help. A large mold infestation or one that resides within your home’s walls or HVAC system requires detailed inspection, fully-fledged protective measures, and expert handling.
Professional Mold Remediation from Rescue Clean 911
This is where services like Rescue Clean 911 come in. As one of the leading mold remediation companies in South Florida, Rescue Clean 911 has a team of experts specifically trained to deal with all forms of mold infestations.
With proper training and the right protective gear, we ensure effective and safe mold removal while preventing further spread within your home.
Our professional remediation process involves not just the removal of the mold but also an assessment of the cause. We help you identify what led to mold growth in the first place so that you can implement preventative measures and stop future infestations from occurring.
Battling green mold might seem daunting, but with our assistance, you don’t have to face this challenge alone. Rescue Clean 911 is ready to offer prompt and efficient mold remediation services, giving you peace of mind that your home is a healthy place for you and your family.
When to Use a Commercial Mold Cleaner (and When Not To)
Dealing with mold can be stressful, and reaching for a commercial mold cleaner might seem like the easiest fix. And in many cases, it is, but it’s not always the right solution. These cleaners often contain mold inhibitors that help prevent spores from coming back, which makes them great for tackling mold that’s visible on surfaces.
 You’ll want to use them on hard, non-porous surfaces, like tiles, sinks, and certain wood surfaces. They’re especially useful in spots where moisture buildup is common, like bathrooms, kitchens, or laundry areas, helping to keep your indoor environment healthier. And don’t forget to wear protective gear like gloves and a mask while cleaning; safety first.
You’ll want to use them on hard, non-porous surfaces, like tiles, sinks, and certain wood surfaces. They’re especially useful in spots where moisture buildup is common, like bathrooms, kitchens, or laundry areas, helping to keep your indoor environment healthier. And don’t forget to wear protective gear like gloves and a mask while cleaning; safety first.
That said, commercial cleaners aren’t effective everywhere. Porous materials, carpets, drywall, or insulation can trap mold deep inside, and spraying a cleaner won’t fully remove it. Even hidden spaces like crawl spaces can hide mold problems that need more than just a surface clean.
One key to long-term success is improving airflow. Using exhaust fans and increasing air circulation in your home helps keep areas dry, which makes it harder for mold to return. So, while a commercial cleaner can kill mold on contact, preventing it from coming back requires tackling moisture and ventilation issues.
Use commercial cleaners for visible mold on non-porous surfaces, but think of them as one tool in your toolbox. Proper ventilation, moisture control, and protective measures are just as important for keeping your home mold-free.
Frequently Asked Questions (FAQ)
Can I remove green mold myself?
Yes, for areas under 10 square feet, using gloves, a face mask, detergent, baking soda, or white vinegar is safe. Larger infestations require professionals.
How quickly does mold grow?
Mold grows rapidly in humid areas with poor air movement, usually within 24-48 hours on wet surfaces.
Is green mold dangerous to pets?
Some molds produce mycotoxins, so exposure to green mold can be dangerous, affecting pets, causing respiratory issues or other potential health effects.
What are the most common causes of green mold?
Moisture leaks, condensation, poor ventilation, and water-damaged materials are the most common causes.
When to Call a Professional Remediation Company
 If mold covers a large area, penetrates porous materials, or keeps returning, it’s time to call experts. Professional remediation ensures green mold and dangerous growth are fully eliminated and prevents a losing battle against recurring spores. They can address:
If mold covers a large area, penetrates porous materials, or keeps returning, it’s time to call experts. Professional remediation ensures green mold and dangerous growth are fully eliminated and prevents a losing battle against recurring spores. They can address:
- Hidden mold in HVAC ducts
- Structural mold in walls and ceilings
- Persistent moisture sources
Professionals can also safely remove mold that grows in high-risk areas and provide long-term prevention tips.
READ: How Long Does Mold Remediation Take? Factors, Processes, and More
Prevention and Long-term Management of Green Mold
After successfully dealing with a green mold infestation, the next logical step is to prevent any future occurrences. This involves keeping the conditions inside your home unfavorable for mold growth and carefully monitoring for any early signs of green mold.
Long-term management of green mold focuses on strategies to prevent green mold growth and reduce the risk of future mold growth. Homeowners should monitor areas where existing mold has been discovered and take proactive steps to maintain dry, well-ventilated spaces.
 Minimizing the Risk of Mold
Minimizing the Risk of Mold
One key prevention tip is to control humidity within your home. Mold thrives in damp areas, so maintaining a dry environment can help keep an infestation at bay. Using fans and dehumidifiers to keep your indoor humidity below 50% can effectively deter mold growth.
Paying attention to the ventilation in your home can also help prevent mold infestations. Especially in areas like your kitchen, bathroom, and basement, where mold often grows unnoticed. Making sure these areas are well-ventilated can prevent the buildup of moisture that fuels mold growth.
Further, make a habit of quickly fixing any leaks in your home. Whether it’s from a pipe, the roof, or anywhere else, even a small amount of accumulated water can serve as a breeding ground for mold. Prompt repair prevents excessive moisture and diminishes the chances of green mold returning.
Call Rescue Clean 911
Lastly, you should have regular mold inspections by professionals like Rescue Clean 911 to stay one step ahead of any potential infestation. Our team can provide expert advice, maintain regular check-ins, and help ensure you never have to deal with the harmful health effects or structural damage caused by green mold.
Green mold, like any other mold, can turn from a minor irritation to a significant problem if not adequately addressed. Nevertheless, armed with knowledge about identification, removal, and prevention, you can ensure a healthier and safer home environment for you and your family. Call Rescue Clean 911 today!
Sources:
Centers for Disease Control and Prevention. “Mold.” Centers for Disease Control and Prevention, October 18, 2023. https://www.cdc.gov/mold/default.htm.
Centers for Disease Control and Prevention. “Cyanobacteria (Blue-green Algae) FAQs.” Centers for Disease Control and Prevention, May 2022. https://www.cdc.gov/habs/pdf/cyanobacteria_faq.pdf.
Centers for Disease Control and Prevention. “Aspergillosis.” Centers for Disease Control and Prevention, October 12, 2023. https://www.cdc.gov/fungal/diseases/aspergillosis/index.html.
Chen, Wenling, et al. “Indoor Mold Exposure and Respiratory Outcomes in Children: A Systematic Review and Meta-Analysis.” Frontiers in Pediatrics, vol. 10, 2022, p. 8271404. https://www.ncbi.nlm.nih.gov/pmc/articles/PMC8271404/.
Centers for Disease Control and Prevention. “Talaromycosis.” Centers for Disease Control and Prevention, October 12, 2023. https://www.cdc.gov/fungal/diseases/other/talaromycosis.html.
Centers for Disease Control and Prevention. “Controlling Mold in Your Home.” Centers for Disease Control and Prevention, October 18, 2023. https://www.cdc.gov/mold/control_mold.htm.
“Beyond Respiratory Issues: Long-term Mould Exposure Side Effects.” National Library of Australia. https://nlr.com.au/articles/mould-exposure-long-term-side-effects
